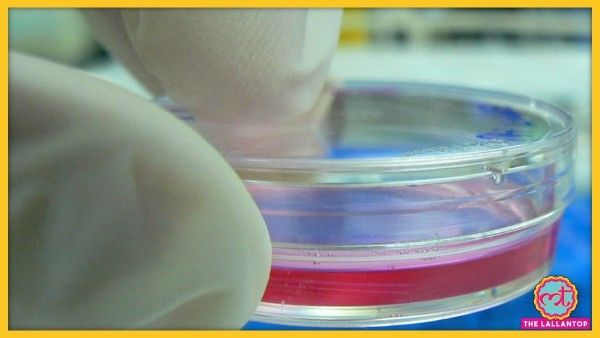
Sale(571)

पहले समझिए, क्या होता है क्लीन मीट या लैब मीट
ऐसा मांस, जिसे पाने के लिए किसी जानवर को मारना न पड़े, वह क्लीन मीट कहा जाता है. इसके दूसरे भी कई नाम हैं जैसे लैब मीट, कल्चर्ड मीट, सेल बेस्ड मीट, इन विट्रो मीट आदि. लैब मीट कहना इसलिए ज्यादा सही होगा, क्योंकि ये मीट पूरी तरह से लैब में पैदा किया जा रहा है, या यूं कहें कि उगाया जाता है. इसे कुछ लोग क्लीन मीट इसलिए भी कहते हैं कि बिना किसी खून-खराबे के ये हासिल किया जाता है. इसे बनाने के लिए लैब में किसी जानवर की कोशिकाओं को कृत्रिम तरीके से उगाया जाता है.

लैब में बने मीट के लिए किसी जानवर को मारने की जरूरत नहीं पड़ती. (फोटो- इट जस्ट)
इस मीट को लैब में बनाते कैसे हैं?
# सबसे पहले जिस जानवर का मीट (मुर्गा, भैंस, बकरा, भेड़ आदि का) उगाना होता है, उसके टिश्यू यानी कोशिका को लेते हैं. यह उस जानवर के मांस का एक छोटा टुकड़ा होता है.
# उसके बाद इस मीट को एक खास तरीके से फिल्टर करते हैं. ऐसा करने से उस कोशिका को निकाला जाता है, जिसे आगे उगाया जा सके. बता दें कि हर कोशिका को उगाना संभव नहीं होता है.
# इस खास कोशिका के मिलने का बाद उसे एक खास तापमान, ऑक्सीजन और माहौल दिया जाता है ताकि कोशिकाओं के बंटने का प्रोसेस शुरू हो सके. असल में हमारे शरीर में भी कोशिकाएं हमेशा बंटती ही रहती हैं. लैब में कोशिकाओं को वैसी ही फीलिंग दी जाती है कि जैसे ये उस शरीर में ही हैं, जहां से उन्हें निकाला गया है.
# ये कोशिकाएं ही धीरे-धीरे साइज में बढ़ने लगती हैं और लैब में मीट या कहें मीट जैसा कुछ तैयार कर देती हैं.
लैब में एक खास तरीके से जानवर के शरीर से लिए टिश्यू को उगाते हैं.
तो क्या लैब मीट का बना मुर्ग मुसल्लम और मटन रोगन जोश भी मिलेगा?
अपने स्वाद के घोड़ों को लगाम दीजिए. सिंगापुर में भी जिस लैब में बने मीट को बेचने की परमिशन दी गई है, वह नगेट की तरह का है. मतलब मीट की बनी एक पकौड़ी जैसा. लैब में मीट बनाना बहुत ही मुश्किल काम है. ऐसे में मुर्ग मुसल्लम और मटन रोगन जोश के बारे में फिलहाल सपना ही देखा जा सकता है. ऐसा न हो पाने की सबसे बड़ी वजह ये हैं.
# जो भी मीट लैब में तैयार किया जा रहा है, वह शरीर के किसी खास हिस्से को लेकर उगाया जा रहा है. ऐसे में जो बन कर तैयार हो रहा है, वह भी उस हिस्से के मीट जैसा ही दिखता है. उसमें न मसल्स होते है और न हड्डी.
# जानवर के मांस के एक टुकड़े में फैट, मसल्स, हड्डी जैसी कई संरचनाएं होती हैं. जबकि लैब में बना मीट एक ढीला मांस का लोथड़ा भर होता है. ऐसे में फिलहाल इसकी मनचाही डिश बनाना मुश्किल काम है.

फिलहाल लैब में बने मीट से सिर्फ सीमित मात्रा में ही डिशेज बनाई जा सकती हैं.
क्या इसको खाना सेफ है?
अमेरिका के सैन फ्रांसिस्को की कंपनी इट जस्ट सिंगापुर में लैब का बना मीट सप्लाई करेगी. इस कंपनी का दावा है कि यह पूरी तरह से सेफ है. इसमें किसी भी तरह के कैमिकल का इस्तेमाल नहीं किया गया है. बता दें कि यह कंपनी पहले ही अमेरिका की मार्केट में लैब के बने अंडे का सीरप बेच रही है. इसे जस्ट एग नाम दिया गया है. यह फेंटे गए अंडे जैसा एक सीरप होता है, जिससे ऑमलेट जैसी कई तरह की डिशेज बनाई जा सकती हैं. ये अंडे का सीरप पूरी तरह से प्लांट बेस्ड है. मतलब इसमें किसी भी तरह के जानवर का इस्तेमाल नहीं किया गया है. चार अंडे के बराबर इस सीरप की कीमत 8 डॉलर या तकरीबन 600 रुपए होती है.

लैब में मीट बनाने वाली अमेरिका की इट जस्ट नाम की कंपनी इसे पूरी तरह सेफ बता रही है. कंपनी अमेरिका में प्लांट बेस्ड अंडे का सीरप पहले से बेच रही है (फोटो - इट जस्ट).
प्लांट बेस्ड मीट वाले आइडिया का क्या हुआ?
वह आइडिया भी साथ-साथ चल रहा है. इस प्रोजेक्ट पर काम करने वाली अमेरिकी की सबसे बड़ी कंपनी इंपॉसिबल मीट ने 2 साल पहले सोयाबीन के पौधे से मीट की एक टिक्की बनाकर दुनिया को चौंका दिया था. यह कंपनी बाकायदा मार्केट में अपनी पैटी (बर्गर के बीच में रखी जाने वाली टिक्की) के साथ उतर चुकी है. इसकी 12 पैटी का एक सेट 60 डॉलर या तकरीबन 4400 रुपए की है.

















.webp?width=120)
.webp?width=120)
.webp?width=120)
.webp?width=120)



